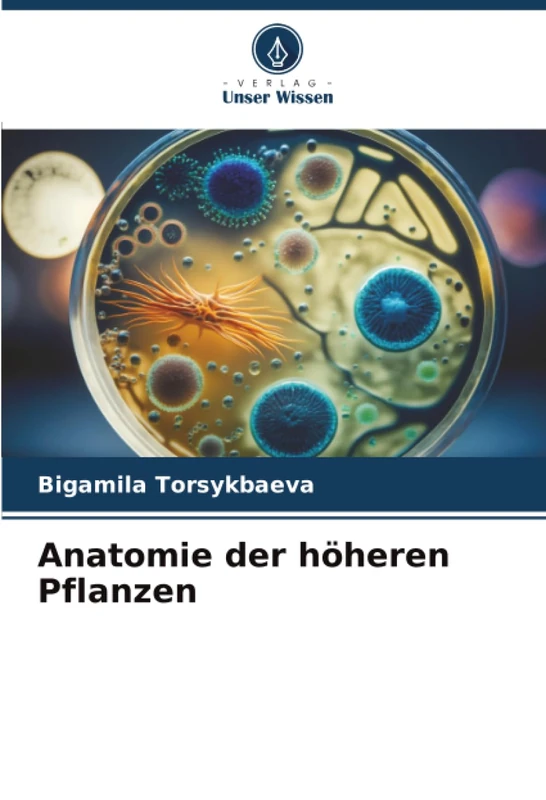
Anatomie der höheren Pflanzen

We can't find the internet
Attempting to reconnect
Something went wrong!
Hang in there while we get back on track

£57.00
Phytochemische Analyse und biologische Aktivitäten von Arzneipflanzen
Price data last checked 108 day(s) ago - refreshing...
We'll watch every seller, every day. One email when your price arrives.
It has never been this cheap. We have no record of a lower price.
£57 today · cheaper than every other day in the last 22 months
NEW HERE?
Amazon shows you one price. We show you all of them.
Tosheroon watches Amazon prices so you don't have to. Every product on Amazon has a price history — we make it visible. Set the price you'd actually pay, and we'll email you the second it gets there. No app, no account, one email.
WHAT'S ON THIS PAGE
when this has been cheap or pricey
where the price is heading next
all-time high & low, recent range
name your number, we'll email you
Price History & Forecast
Grey patches = out of stock. Cheaper = lower on the chart. Hover for exact prices.
Last 558 days • 558 data points (No recent data available)
Price Distribution
Price distribution over 558 days • 1 price levels
Price Analysis
Most common price: £57 (558 days, 100.0%)
Price range: £57 - £57
Price levels: 1 different prices over 558 days
Product Specifications
- Format
- paperback
- ASIN
- 6205250527
- Domain
- Amazon UK
- Release Date
- 13 October 2022
- Listed Since
- 14 October 2022
Barcode
No barcode data available
Similar Products You Might Like

Phytochemische und pharmakologische Eigenschaften indischer Arzneipflanzen

Pflanzliche Arzneimittelformulierungen - ein Segen der Natur

Arzneipflanzen und IPRs: Eine Monographie der Heilpflanzen

Arzneipflanzen: Nahrung, die heilt

Phytosoziologische Merkmale und multivariate Analyse

Biochemie der Pflanzen

Phytochemikalien aus Dalbergia stipulacea Roxb & Morina longifolia Wall

Antikrebsanalyse bei Corynandra Chelidonii: Phytochemische Studien an Corynandra Chelidonii

Untersuchung Von Biologisch Aktiven Verbindungen Durch Katalytische Reaktionen

Neuroprotektive Aktivität von Quercetin: Natriumfluorid und Quercetin

LABORHANDBUCH ZUR PFLANZENBIOCHEMIE

LEHRBUCH DER ANORGANISCHEN MEDIZINISCHEN CHEMIE

Pharmakologische Untersuchungen zu Taverniera cuneifolia (Roth) Arn

Kommerzieller Anbau von Heilpflanzen in Tamilnadu

Ethnobotanik: Eine dynamische Beziehung zwischen Pflanzen und Menschen

Pflanzenphysiologie

Fernerkundungsüberwachung von Nutzpflanzen: Fallstudien
Anatomie der höheren Pflanzen

Biopharmazeutika Aufkommende Trends: in der Medikamentenentwicklung und Biotechnologie

Psychopharmaka und oxidativer Stress bei AKUTEN GIFTUNGEN

Klinische Pharmazie

Pharmazeutisches Marketing in Indien: Ethische Perspektive

Medikamente für das Verdauungssystem: Abstract von Therapeutische Chemie
